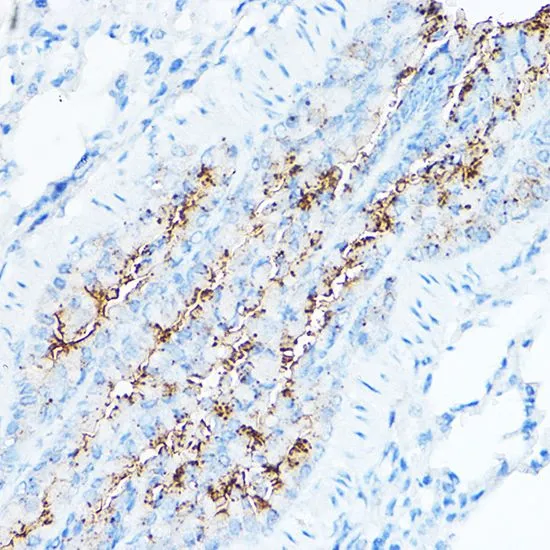

ICC/IF analysis of C6 cells using GTX64544 TMPRSS2 antibody. Blue : DAPI Dilution : 1:50
TMPRSS2 antibody
GTX64544
ApplicationsImmunoFluorescence, Western Blot, ImmunoCytoChemistry, ImmunoHistoChemistry, ImmunoHistoChemistry Paraffin
Product group Antibodies
ReactivityHuman, Mouse, Rat
TargetTMPRSS2
Overview
- SupplierGeneTex
- Product NameTMPRSS2 antibody
- Delivery Days Customer9
- Application Supplier NoteWB: 1:500 - 1:2000. ICC/IF: 1:50 - 1:200. IHC-P: 1:50 - 1:200. *Optimal dilutions/concentrations should be determined by the researcher.Not tested in other applications.
- ApplicationsImmunoFluorescence, Western Blot, ImmunoCytoChemistry, ImmunoHistoChemistry, ImmunoHistoChemistry Paraffin
- CertificationResearch Use Only
- ClonalityPolyclonal
- ConjugateUnconjugated
- Gene ID7113
- Target nameTMPRSS2
- Target descriptiontransmembrane serine protease 2
- Target synonymsPRSS10, transmembrane protease serine 2, epitheliasin, serine protease 10, transmembrane protease, serine 2
- HostRabbit
- IsotypeIgG
- Protein IDO15393
- Protein NameTransmembrane protease serine 2
- Scientific DescriptionThis gene encodes a protein that belongs to the serine protease family. The encoded protein contains a type II transmembrane domain, a receptor class A domain, a scavenger receptor cysteine-rich domain and a protease domain. Serine proteases are known to be involved in many physiological and pathological processes. This gene was demonstrated to be up-regulated by androgenic hormones in prostate cancer cells and down-regulated in androgen-independent prostate cancer tissue. The protease domain of this protein is thought to be cleaved and secreted into cell media after autocleavage. Alternatively spliced transcript variants encoding different isoforms have been found for this gene. [provided by RefSeq, Sep 2008]
- ReactivityHuman, Mouse, Rat
- Storage Instruction-20°C or -80°C,2°C to 8°C
- UNSPSC12352203
References
- Li Y, Wang K, Sun H, et al. Omicsynin B4 potently blocks coronavirus infection by inhibiting host proteases cathepsin L and TMPRSS2. Antiviral Res. 2023,214:105606. doi: 10.1016/j.antiviral.2023.105606Read this paper
- Lee CY, Nguyen AT, Doan LH, et al. Repurposing Astragalus Polysaccharide PG2 for Inhibiting ACE2 and SARS-CoV-2 Spike Syncytial Formation and Anti-Inflammatory Effects. Viruses. 2023,15(3). doi: 10.3390/v15030641Read this paper

![TMPRSS2 antibody [HL2759] detects TMPRSS2 protein at cytoplasm by immunohistochemical analysis. Sample: Paraffin-embedded rat kidney. TMPRSS2 stained by TMPRSS2 antibody [HL2759] (GTX639624) diluted at 1:100. Antigen Retrieval: Citrate buffer, pH 6.0, 15 min](https://www.genetex.com/upload/website/prouct_img/normal/GTX639624/GTX639624_T-45292_20240215_IHC-P_R_24030600_421.webp)


